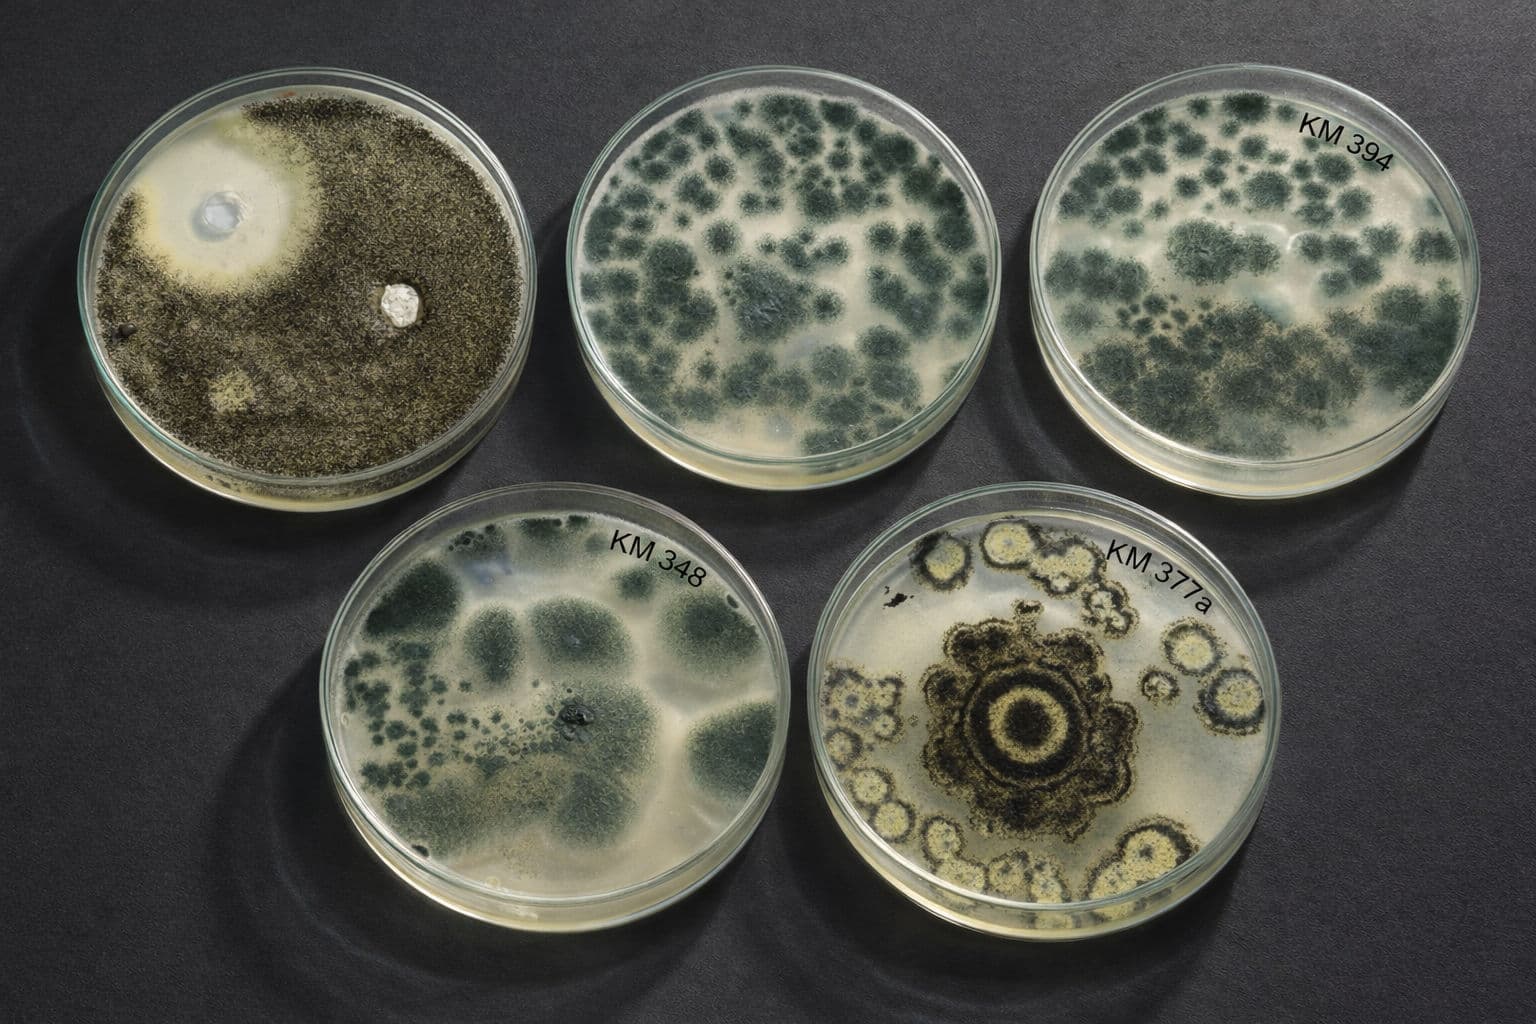
Microbial Culture Analysis

Biotech Research
for Scientific Innovation
SHRIM Biotech provides institutional-grade laboratory infrastructure for advanced research, biotechnology internships, and structured dissertation and Ph.D. support.

Research Contributions & Impact
+
Patents Granted
+
International Publications
+
Research Publications
+
Research Collaborations
Institutional Strength & Experience
+
Years of Experience
+
Workshops Conducted
+
Candidates Trained
Advancing Scientific Innovation
SHRIM Biotech provides institutional-grade laboratory infrastructure for advanced research and academic support.

Bridging the gap between theoretical biotechnology and real-world industrial research through guided laboratory methodologies.
Our lab empowers students through structured internships and dissertation support, providing the practical exposure required for PhD-level research.
We focus on cultivating a professional environment where scientific curiosity meets disciplined methodology, ensuring that our researchers are prepared for the complex challenges of modern biotechnology and industrial research.
Our Areas of Work
A specialized research infrastructure bridging the gap between theoretical biotechnology and industrial innovation.

Academic Outreach
Internship Programs
Hands-on laboratory training providing practical exposure in biotechnology.
Student Support
Dissertation Support
Structured guidance for undergraduate and postgraduate dissertation projects.
Higher Research
PhD research Support
Advanced experimental support and scientific validation for PhD scholars.
Scientific Expertise & Capabilities
Plant Tissue Culture
Specialized techniques for clonal propagation, genetic transformation, and metabolite production. Our facility provides a sterile environment for studying plant growth regulators.
Suspension Culture
Cell culture methodologies for studying growth kinetics and scale-up biological processes. We focus on bioreactor-level optimization and producing bioactive compounds.
Endophytic Fungi Research
Molecular identification and pharmacological screening of symbiotic fungi residing in plant tissues. We explore their potential in producing novel metabolites.
Research & Training Programs
Comprehensive research guidance, internships, and scientific training programs designed for students, researchers, and academic institutions.
PhD Research Work
Advanced experimental research guidance for PhD scholars including laboratory access, scientific validation, and mentorship support.

MSc Dissertation Support
Structured laboratory guidance for MSc dissertation projects with hands-on experimentation and research methodology support.

MSc & BSc Internships
Practical laboratory internship programs providing real-world exposure to microbiology, biotechnology, and plant tissue culture techniques.

Short & Long-Term Training
Specialized laboratory training programs ranging from short-term practical sessions to extended research training.

Online & Offline Workshops
Scientific workshops and educational sessions designed to enhance biotechnology research skills and laboratory techniques.

Customized Academic & Industry Training
Tailored training programs for students, faculty members, and industry professionals based on specific research and laboratory needs.

Ongoing Research Projects
High-precision laboratory initiatives focusing on phytochemical analysis, biotechnology, and molecular innovation.
Soil and Water Profiling Research
Ongoing research project focusing on soil, water, and phytochemical profiling for environmental and agricultural biotechnology.

Phytochemical Studies
Analysis of total phenolic content (TPC), flavonoids (TFC), and antioxidant activity in plant-based compounds.

Antibiotic Susceptibility Testing
Evaluation of microbial resistance and effectiveness of antibiotics against various bacterial strains using standardized methods.

Collaborate on Applied Research
We provide the laboratory infrastructure and specialized expertise to bring complex biotechnology projects to life. Join us in advancing scientific innovation.
Our Collaborations
We work with leading academic and research institutions to advance biotechnology innovation.

Indira Gandhi National Tribal University (IGNTU), Amarkantak
Ministry of AYUSH Research Project
Amarkantak, M.P.

Centre for Biodiversity Exploration & Conservation (CBEC)
Research Organization
Jabalpur / Bhopal, M.P.

Parul University
Faculty of Pharmacy & Applied Sciences
Vadodara, Gujarat

Eklavya University
Department of Basic and Applied Sciences
Damoh, M.P.
Institutional Leadership
A synergy of visionary leadership and scientific expertise driving biotechnology innovation.

Mr. Shrirang Gokhale
Founder & Chairman
“Building a foundation for scientific excellence in Central India.”
As the visionary founder, he established SHRIM Bioinnovation & Research with the core objective of making advanced biotechnology accessible for regional development and academic growth. His leadership focuses on bridging the gap between industry requirements and academic training, ensuring that the laboratory remains at the forefront of scientific innovation while fostering a culture of practical research and ethical scientific inquiry.

Dr. Mamta Gokhale
Director & Lead Scientist
“Advancing learning through practical experimentation.”
Directing the laboratory's scientific mission, she oversees all research operations, plant tissue culture advancements, and academic mentorship programs. With over two decades of experience in high-fidelity microbiology and plant-based research, she has been instrumental in developing standardized protocols for clonal propagation and genetic validation, guiding thousands of researchers through specialized laboratory training and dissertation support.
Consolidated Team Experts
Scientific experts and strategic board members dedicated to standardizing biotechnology research excellence.

Mr. Shridhar Gokhale
Adviser

Mrs. Manisha Bhave
Partner

Dr. Rohit Sharma
Research Advisor

Dr. Radhika Khatri
Research Associate

Mr. Jitendra Nema
Technical Assistant
Laboratory Gallery
A glimpse into our advanced biotechnology infrastructure, research facilities, and scientific experiments.

Connect with Our Researchers
Our scientific board is available for academic consultation, dissertation research support, and PhD collaborations at our Jabalpur facility.
Start Your Research Journey With Us
Establish your scientific foundation at Jabalpur's premier laboratory facility for plant tissue culture & microbiology research excellence.
Institutional Contacts
+91 9826310755
+91 8461049909
Send Laboratory Inquiry
Institutional Review Portal